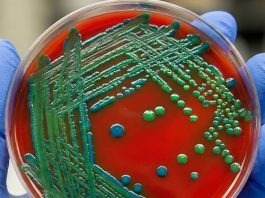
Metisiline Dirençli Staphylococcus Aureus (MRSA) Enfeksiyonu

AKIL KARTLARI
Tiyokolşikosid (Muscoril) Ampul Uygulama
Tiyokolşikosid (Thiocolchicoside: Muscoril), anti-inflamatuar ve analjezik etkileri olan bir kas gevşeticidir Doğal bir ilaç olan kolşikozitin kükürtlü yarı sentetik türevidir. Ağrılı kas
spazmlarının semptomatik tedavisi...
Erişkin Temel Yaşam Desteği AHA 2025
Amerikan Kalp Derneği’nin (AHA) 2025 Erişkin Temel Yaşam Desteği (TYD) kılavuzu, önceki kılavuzların üzerine güncel bilimsel veriler eklenerek yeniden düzenlenmiştir. Bu bölümde, erişkin bir...
AKADEMİK SUNUMLAR
Daha Fazla
Alüminyum Fosfit Zehirlenmelerinin Acil Yönetimi
Alüminyum fosfit, tarım ve depolama sektöründe yaygın olarak kullanılan güçlü bir pestisittir (böcek ilacı). Ancak toksisitesi son derece yüksek olduğundan, zehirlenmeleri küresel ölçekte ciddi...
Erişkin Hastalarda Yabancı Cisim Tıkanıklığı AHA 2025
Yabancı cisim ile hava yolu tıkanması (FBAO), yaygın görülen bir acil durumdur ve 2021 yılında 5000’den fazla vaka ile Amerika Birleşik Devletleri’nde kazara ölümlerin...
OLGU SUNUMLARI
Daha Fazla
54 Yaş Göğüs Ağrısı Erkek Hasta
Hasta Bilgisi
Yaş / Cinsiyet: 58 yaşında erkekBaşvuru Nedeni: Ani başlayan göğüs ağrısı
Birincil Değerlendirme
Bilinç: Açık, koopere
Solunum: Hafif dispneik, solunum sayısı 22/dk
Dolaşım: Soğuk,...
65 Yaş Yılan Isırma Olgusu
Yılan ısırıkları çoğunlukla insan ile yılanın aniden karşılaşması sonucu ortaya çıkar. Yılan, kendini tehlikede hissedip kaçacak alan bulamadığında savunma içgüdüsüyle saldırabilir. Türkiye’de yılan ısırıkları...
SOSYAL ACİL
Covid-19 KPR Kamu Spotu
Biliyor Musunuz?
112'yi zamanında aramamak hayatlara mal olabilir.
İlk yardım öğrenin, hayat kurtarın!
Eğer siz veya sevdikleriniz bir kalp krizi, felç semptomu ya da yaşamı tehdit eden...
Doktor Olmak İsteyenlere Tecrübeler
Başlıkata da belirttiğim gibi yazacaklarım profesyonelce şeyler değil sadece benim tecrübelerim ve gördüklerim yani fakülteden fakülteye değişiklik gösterebilir veya kişiden kişiye o yüzden sorumluluk...
Sevdiklerini Sensiz Bırakma Kamu Spotu
Araç kullanırken cep telefonuyla arama yapmak, çalan telefona cevap vermek, numara çevirmek gibi davranışlar sürücünün dikkatinin dağılmasına, konsantrasyonunun bozulmasına neden olarak kazaya yol açabilir....
Vinnie Jones Kalp Masajı
İngiliz Kalp Vakfı tarafından hazırlanan bu videoda Vinnie Jones bir mafya babasını canlandırıyor. Amaç eğlenceli şekilde kalp masajının önemine vurgu yapmak..
HABERLER
- Advertisement -
Alüminyum Fosfit Zehirlenmelerinin Acil Yönetimi
Alüminyum fosfit, tarım ve depolama sektöründe yaygın olarak kullanılan güçlü bir pestisittir (böcek ilacı). Ancak toksisitesi son derece yüksek olduğundan, zehirlenmeleri küresel ölçekte ciddi...
Erişkin Hastalarda Yabancı Cisim Tıkanıklığı AHA 2025
Yabancı cisim ile hava yolu tıkanması (FBAO), yaygın görülen bir acil durumdur ve 2021 yılında 5000’den fazla vaka ile Amerika Birleşik Devletleri’nde kazara ölümlerin...
Erişkin Temel Yaşam Desteği AHA 2025
Amerikan Kalp Derneği’nin (AHA) 2025 Erişkin Temel Yaşam Desteği (TYD) kılavuzu, önceki kılavuzların üzerine güncel bilimsel veriler eklenerek yeniden düzenlenmiştir. Bu bölümde, erişkin bir...
Düzenli Dar Kompleks Taşikari Önerisi AHA 2025
Yetişkinlerde Düzenli Dar Kompleks Taşikardi Tedavisi için Öneriler
COR
LOE
Öneriler
1
B-R
1. Düzenli dar kompleks taşikardilerin akut tedavisinde vagal manevralar önerilir.
1
B-R
2. Düzenli dar kompleks taşikardilerin akut tedavisi için...
Polimorfik Ventriküler Taşikardi AHA 2025 Tedavi Önerileri
Polimorfik Ventriküler Taşikardi Olan Yetişkinlerin Tedavisi İçin Öneriler
COR
LOE
Öneriler
1
B-NR
1. Süregen polimorfik ventriküler taşikardisi olan erişkinlerde acil senkronize olmayan (unsynchronized) şok önerilir.
2b
C-LD
2. Uzamış QT aralığı (torsades...
Erişkin Nabızlı Taşikardi Algoritması AHA 2025
Klinik duruma göre kalp hızının uygunluğunu değerlendir
Taşikardilerde kalp hızı genellikle ≥150/dk olur.
Başlangıç değerlendirme ve destek
Hava yolunu açık tut; gerektiğinde solunuma yardım et.
...
Difüzyon MR Yorumlanması
Difüzyon ağırlıklı manyetik rezonans görüntüleme, yaygın olarak akut serebral iskemide kullanılmaktadır. Genellikle kontrastsız beyin BT görüntülemesinin ardından serebral iskeminin diğer ani nörolojik fonksiyon kaybına...
Pediatrik Temel Yaşam Desteği – “Eve Götürülecek 10 Mesaj” AHA 2025
AHA 2025 güncellemeleri, çocuk ve bebeklerde Temel Yaşam Desteği yaklaşımının özünü yeniden şekillendiriyor. En kritik noktalar artık çok net: Solunum ve oksijenasyon pediatrik arrestin...
Opioid Zehirlenmeleri (İntoksikasyonu)
Opioidler (opiyatlar), esas olarak şiddetli ağrıların kontrolü için kullanılan ve haşhaş bitkisinden (afyon) elde edilen narkotik ilaçlardır. Morfin ve kodein gibi doğal kaynaklı olanları...
Viral Konjonktivitler Acil Yaklaşım
Kırmızı gözün en sık nedenleri arasında sayılan konjonktivitler, gözün konjonktiva tabakasının enflamasyonu ve göz kızarıklığının yaygın bir nedenidir. Konjonktivitin en yaygın üç nedeni viral,...
Okülomotor (3.) Sinir Felci
Üçüncü kranial sinir (n. oculomotorius), göz hareketlerinin büyük çoğunluğundan, pupilla refleksinden ve göz kapağının kaldırılmasından sorumlu olan karma bir motor sinirdir. Parasempatik ve somatik...
Gastrointestinal Sistem Kanamaları Genel Bakış
Gastrointesinal sistem(GİS) kanamaları acil servis başvurularının ölümcül sebeplerinden birisidir. GİS kanamaları değerlendirilirken GİS 2 bölümde incelenir. Duodenumu asan Trietz ligamantının üzerinde kalan bölge üst...
Ablasyo Plasenta (Plasenta Dekolmanı) Acil Yaklaşım
Plasenta dekolmanı, doğumun ikinci evresi tamamlanmadan önce plasentanın uterus duvarından erken ayrılmasıyla karakterize ciddi bir obstetrik acil durumdur. Gebeliğin ikinci yarısında görülen vajinal kanamanın...
Öne Çıkan Noktalar Kardiyopulmoner Resüsitasyon (CPR) Kılavuzu 2025 AHA
Bu özet, 2025 Amerikan Kalp Derneği (AHA) Kardiyopulmoner Resüsitasyon (CPR) ve Acil Kardiyovasküler Bakım (ECC) kılavuzlarındaki ana konuları ve değişiklikleri özetlemektedir.2025 kılavuzları; yetişkin, pediatrik...